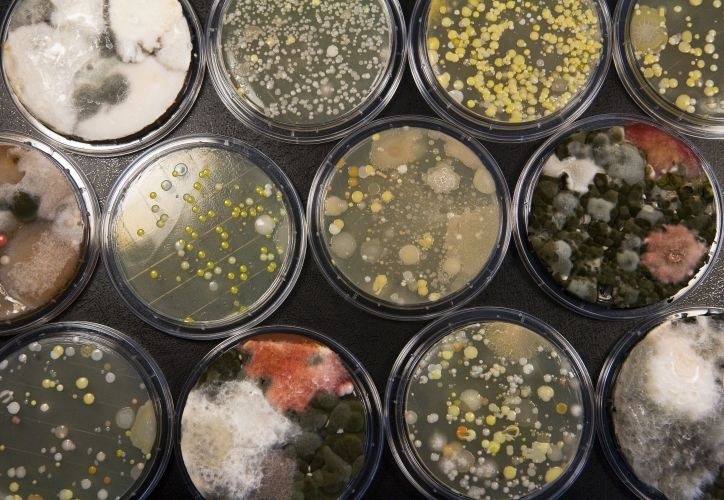
Você sabia que cada 6,4 cm² de pele do corpo humano tem cerca de 32 milhões de bactérias? Na foto, placas revelam a concentração de bactérias - Rafael Hupsel/Folhapress

Sistema respiratório - A respiração nos humanos e em outros animais

A grande maioria dos seres vivos necessita do oxigênio para realizar o metabolismo celular e precisa eliminar o gás carbônico (dióxido de carbono) resultante desse processo. A essa troca desses gases damos o nome de respiração.
Os seres vivos conseguem resistir a restrições alimentares, pois sobrevivem com a gordura ou outros alimentos armazenados nos corpos. Também sobrevivem, a períodos menores, com restrições de água, pois possuem mecanismos para armazená-la e/ou economizá-la. Porém, o tempo de sobrevivência à falta de oxigênio é muito pequeno, pois é pouco armazenado nos corpos. Se você parar de respirar, só será possível permanecer vivo por no máximo uns sete minutos.
Você sabia?
O ar do espirro humano pode viajar a uma velocidade de 160 km/h ou mais - outra boa razão para você cobrir seu nariz e boca quando espirrar, ou desviar a cabeça quando ouvir um vindo em sua direção
Fonte: www.saude.hsw.uol.com.brA vida originou-se na água. Uma grande quantidade indivíduos aquáticos continua utilizando o oxigênio dissolvido nas águas, já que é impossível retirar o oxigênio da molécula de água. No decurso da evolução, muitos seres vivos mudaram-se para o ambiente terrestre e passaram a retirar o oxigênio do ar, o que originou profundas mudanças no processo de respiração.
Processos respiratórios
Em seres unicelulares, como os protozoários (ameba), as trocas gasosas são feitas através da membrana do corpo, da parede celular. Os grupamentos atômicos dos gases passam de um lado para outro da membrana, da região em que estão mais concentrados para as regiões onde estão menos concentrados. Esse processo é conhecido como difusão dos gases.
Em indivíduos pluricelulares, como esponjas, águas vivas e outros, os gases se difundem pelas células dos tecidos do corpo.
No caso dos animais maiores e mais complexos, o processo de difusão apenas não é suficiente, pois neles os diferentes tecidos formam órgãos que, muitas vezes, estão distantes da superfície onde ocorre a troca gasosa.
Apesar de existirem diferentes estruturas para realizar-se nos diferentes animais, em todos os eles a respiração conta com uma membrana úmida e permeável, através da qual os grupamentos atômicos do oxigênio e gás carbônico se difundem saindo e entrando de seus corpos.
Os mecanismos respiratórios variam de acordo com as estruturas respiratórias de cada indivíduo: difusão auxiliada por um sistema de transporte através de capilares (minhoca); traqueias (barata, abelha, piolho de cobra); brânquias (peixe); pulmão (ser humanos, rato, cachorro...). O aparelho respiratório de todos os vertebrados terrestres - a maioria dos anfíbios (sapos), dos répteis (cobras e lagartos), aves (pássaros) e mamíferos (cavalos, cachorros, seres humanos) - possui pulmões.
Os animais que vivem no meio terrestre enfrentam ainda o problema da perda da água. Uma grande superfície externa e úmida, que propicia as trocas gasosas, aumenta muito a perda de água. Assim essa superfície "precisou" ser reduzida. É a superfície de contato do corpo com o ambiente. Os animais necessitam de água para sua sobrevivência, se eles estão diretamente em contato com um meio aéreo, sem proteção, perderão água com facilidade e secarão. Se não for possível repor, o animal secará mesmo e morrerá.
A pele de um anfíbio, por exemplo, é extremamente fina, quando fora d'água esse animal perde muito rapidamente água para o meio ambiente. Se não retornar ao meio aquático para suprir a perda de água ressecará e morrerá. Também se podem observar as nossas mucosas nasais em tempo muito seco, que ressecam e podem até sangrar. Os problemas respiratórios aparecem nessas épocas.
A respiração
Você sabe explicar como colocamos ar em nossos corpos? Por movimentos musculares, em parte voluntários, o diafragma e as costelas são abaixados, promovendo um aumento do volume do tórax. A pressão nos pulmões fica diminuída (pressão negativa) em relação à pressão externa (atmosférica), promovendo a entrada do ar exterior nos pulmões. Posteriormente, o relaxamento do diafragma e da musculatura entre as costelas causa a diminuição do volume dos pulmões, forçando o ar para fora, o que produz a expiração.
Quando fazemos uma grande inspiração, o ar do ambiente entra pelo nosso nariz ou boca, passa pela faringe, laringe, traqueia, brônquios e bronquíolos, até chegar aos alvéolos pulmonares, enchendo nossos pulmões. É nos alvéolos pulmonares que ocorrerá a troca de gases entre a atmosfera e o nosso sangue, que levará o oxigênio às diferentes células do corpo e delas vai retirar o gás carbônico.
Os brônquios chegam aos pulmões, onde se dividem formando tubos menores (os bronquíolos), os quais chegam aos alvéolos pulmonares. Os alvéolos pulmonares possuem paredes muito finas e estão recobertos por uma quantidade enorme de capilares. Dessa forma ocorre aumento grande da superfície de contato entre o ar, que entrou nos pulmões, e o sangue.
É nos alvéolos que será feita a troca de gases entre o ar e o sangue. O sangue rico em gás carbônico (sangue venoso) chega aos alvéolos pulmonares pelos capilares, e entra em contato com o ar que preenche os alvéolos por sua fina camada de células achatadas. Aí ocorrem as trocas gasosas. O sangue libera o gás carbônico (dióxido de carbono) e capta o oxigênio, se transformando de venoso em sangue arterial (rico em oxigênio).
Enfim, a respiração pode ser dividida em três etapas:
O ar inspirado é mais frio que o organismo e seu grau de umidade é baixo. Para diminuir as diferenças de temperatura e umidade entre o ar do meio ambiente e o sangue, o ar é filtrado, aquecido e umedecido ao longo do trajeto que percorre. Disso, podemos concluir que a expiração "rouba" do corpo energia térmica e água.
O circuito dos gases em nosso corpo O transporte de gases pelo sangue é feito por pigmentos respiratórios e pelo plasma. Na maioria dos vertebrados a hemoglobina (pigmento respiratório dos glóbulos vermelhos - hemácias) combina-se com o oxigênio formando a oxiemoglobina na superfície de troca respiratória. Nos tecidos, a hemoglobina libera o oxigênio, seguindo de volta aos pulmões.
Nos alvéolos pulmonares, a concentração de oxigênio do ar é elevada, e no sangue, que circula nos capilares, a concentração de oxigênio é baixa. Essa diferença resulta na difusão do oxigênio para dentro do sangue.
O gás carbônico é constantemente produzido pelas células durante o metabolismo celular (respiração celular), gerando uma diferença de concentração entre o interior da célula e seu exterior (espaço intercelular ou interstícios), e uma consequente difusão desse gás carbônico para o líquido intersticial. Agora o líquido intersticial passa a ter uma concentração maior de gás carbônico que o plasma sanguíneo, o que causa uma difusão para o capilar. O gás carbônico é transportado pela hemoglobina ou dissolvido no plasma.
Transformações químicas A concentração de gás carbônico, no plasma, modifica a afinidade da hemoglobina ao oxigênio. Nos tecidos, onde a concentração de gás carbônico é alta, a hemoglobina tem sua afinidade pelo oxigênio diminuída, liberando-o para os tecidos; nos pulmões, onde a concentração de gás carbônico é baixa, a afinidade pelo oxigênio aumenta, fazendo com que a hemoglobina se ligue a ele.

ID: {{comments.info.id}}
URL: {{comments.info.url}}
Ocorreu um erro ao carregar os comentários.
Por favor, tente novamente mais tarde.
{{comments.total}} Comentário
{{comments.total}} Comentários
Seja o primeiro a comentar
Essa discussão está encerrada
Não é possivel enviar novos comentários.
Essa área é exclusiva para você, assinante, ler e comentar.
Só assinantes do UOL podem comentar
Ainda não é assinante? Assine já.
Se você já é assinante do UOL, faça seu login.
O autor da mensagem, e não o UOL, é o responsável pelo comentário. Reserve um tempo para ler as Regras de Uso para comentários.